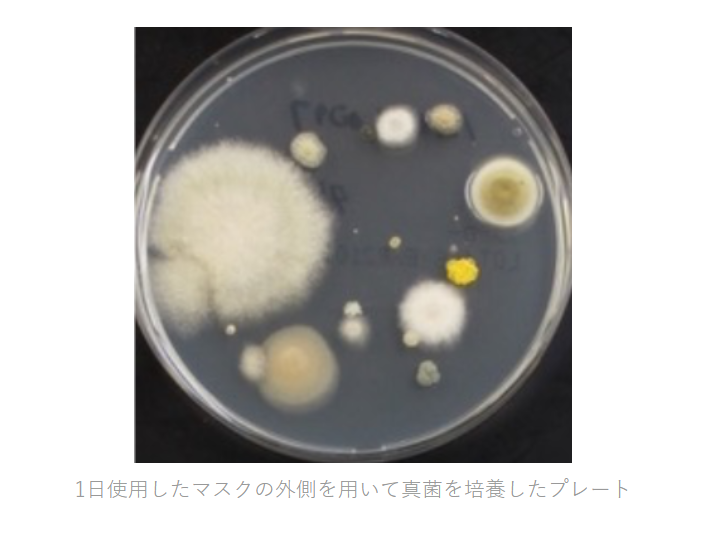

-
142. 匿名 2022/07/20(水) 17:47:57
>>59
マスクしていない人、すごく気になる
正直そばに寄ってほしくない+272
-86
-
971. 匿名 2022/07/20(水) 18:57:54
>>142
屋外で1人ならいいでしょうよ+86
-0
-
1946. 匿名 2022/07/20(水) 20:50:18
>>142
コロナ脳のマスク依存症かな?![]()
+44
-21
-
2291. 匿名 2022/07/20(水) 21:23:01
>>142
こちらはこの暑い中マスクして苦しくないのかな?熱中症によくならないなーと思ってます。
未だにマスクが意味あるものだと思えることも不思議。
マスク1分も着けてたらすごく苦しいんだけど、ずっと着けてる人達は苦しくないんですか?
マスクつけない側から見ると本当に不思議。+59
-38
-
2366. 匿名 2022/07/20(水) 21:31:51
>>142
マスクしてない人を感染者扱いしてるの?
それコロナ脳だよ
世界陸上みた?あれ見て不安になる感じ?
それとも海外は違うから〜ってやつ?
日本だけだよこんな馬鹿みたいにマスクしてんの
犯罪者も犯罪予備軍もマスクしたらバレにくいもんね、この間の銃撃事件もいい例。マスクにサングラスでも怪しまれないおかしな社会+52
-27
-
2939. 匿名 2022/07/20(水) 22:43:50
>>142
室内でマスクしてない人は嫌だよねー
外は今暑いしある程度距離あれば気にしないけど+31
-16
-
3931. 匿名 2022/07/21(木) 01:18:00
>>142
そうなんだ!ただ、マスクは強制じゃないから、貴方から避けるべきだね。すれ違うだけで移るような病だと思ってるのかな、完全思考停止してるね。+19
-3
-
4659. 匿名 2022/07/21(木) 06:32:19
>>142
マスク信仰してるあなたがしっかり二重に口オムツしてれば感染しないんじゃないんですかー?+13
-5
-
4681. 匿名 2022/07/21(木) 06:41:48
>>142
未だにこんなこと言ってる人いるんだ…
たとえば電車で素顔で黙っている人とマスクして大声で喋ってる人、果たしてどちらが常識人かな?+13
-11
-
4700. 匿名 2022/07/21(木) 06:52:34
>>142
マスクって意味あんの?+13
-4
-
4710. 匿名 2022/07/21(木) 06:56:48
>>142
ガルの反マスクは異常+13
-7
-
6262. 匿名 2022/07/21(木) 13:19:40
>>142
もうマスクしてようが、関係ないし全然気にならないなー。むしろちっさい子に炎天下でマスクさせてる方が気になるわ、、大丈夫なんかなと+21
-2
削除すべき不適切なコメントとして通報しますか?
いいえ
通報する